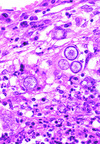
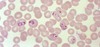
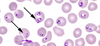
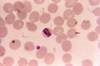

Rapid Review 2 Flashcards
(200 cards)
neutralizing substance for
Sda
guinea pig urine
neutralizing substance for
P1
hydatid cyst fluid
and
pigeon eggs
neutralizing substance for
H
saliva
Ulex europaeus
lotus tetragonolobus
neutralizing substance for
Le a
saliva
neutralizing substance for
I (big i)
breast milk
neutralizing substance for
chido
plasma
neutralizing substance for
rodgers
plasma
neutralizing substance for
A1
dolichos biflorus
neutralizing substance for
B
bandeiraea simplicifolia
neutralizing substance for
T
arachis hypogaea
neutralizing substance for
N
vicea graminea
generally insignificant allo antibodies
LoveLy & Pretty MeaNingless
Le a
Le b
P1
M
N
when should you use an F test?
to decide if one test is more precise than the other
(i.e. how different are the distributions of 2 data sets)
on a Lineweaver Burke plot, what is the y intercept?
1 over Vmax
on a Lineweaver Burke plot, what is the x intercept?
1 over Km (Michaelis constant)
how do competitive inhibitors relate to a drug without an inhibitor?
same y intercept
different x intercept (bc Km increases)
how do non-competitive inhibitors relate to a drug without an inhibitor?
same x intercept
different y intercept (bc they alter V and Vmax)
on a Lineweaver Burke plot, what is the x axis?
1 over [S]
on a Lineweaver Burke plot, what is the y axis?
1 over V
put the thyroid hormones in order from most to least metabolically active
T3 > T4 > rT3
Best marker for pancreatic insufficiency
fecal elastase test (abnormal = low, <100)
what happens to the pH, pO2, and pCO2 of blood if you leave it in the tube/syringe for a while?
pH goes down
pO2 goes down
pCO2 goes up
pO2 goes down & pCO2 goes up bc the pyruvate cycle is going
what happens to the pH, pO2, and pCO2 of blood if you leave it open to ambient air for a while?
pH goes up
pO2 goes up
pCO2 goes down
it starts to ~become the air
Wilson disease
mode of inheritance & gene
auto recessive
ATP7B mutation